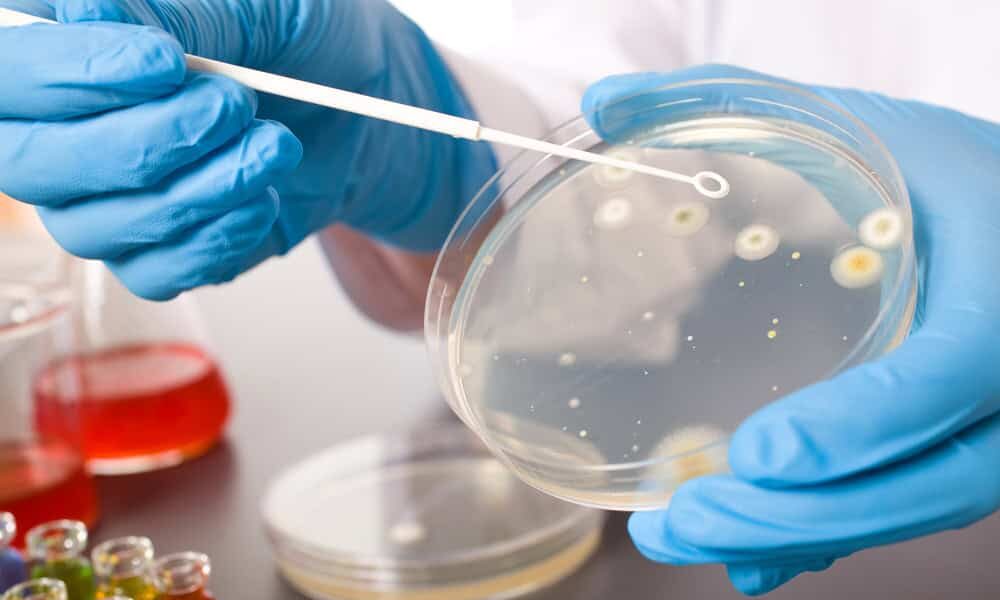

Για εγκληματική χαλαρότητα στον τρόπο αντιμετώπισης των νοσοκομειακών λοιμώξεων, κατηγορεί η ΠΟΕΔΗΝ την ηγεσία του υπουργείου Υγείας και τη Διοίκηση του ΚΕΕΛΠΝΟ.
Όπως καταγγέλλει, η τελευταία φορά που έγιναν έλεγχοι στις Μονάδες Τεχνητού Νεφρού (ΜΤΝ) για παθογόνα μικρόβια από το Κεντρικό Εργαστήριο Δημόσιας Υγείας (ΚΕΔΥ), που είναι υπό την ευθύνη του ΚΕΕΛΠΝΟ, ήταν τον Φεβρουάριο του 2017. Αιτία ισχυρίζεται πως είναι η έλλειψη χρηματοδότησης για την αγορά αντιδραστηρίων. Για τον ίδιο λόγο, συμπληρώνει η ΠΟΕΔΗΝ, δεν μπορεί να ελεγχθεί το νερό ύδρευσης των νοσοκομείων για βακτηρίδια όπως η λεγιονέλλα.
«Οι ΜΤΝ συνδέονται με το δίκτυο ύδρευσης των Νοσοκομείων. Οι δειγματοληπτικοί έλεγχοι στις ΜΤΝ για την ύπαρξη παθογόνων μικροβίων πρέπει να γίνονται κάθε 1 ½ μήνα και για legionella στο νερό ύδρευσης κάθε 6 μήνες. Πολλά νοσοκομεία έχουν 1 χρόνο να κάνουν έλεγχο, ενώ 7 μήνες τώρα το ΚΕΔΥ δεν ελέγχει τα υγρά που χρησιμοποιούνται στα μηχανήματα αιμοκάθαρσης στις ΜΤΝ» τονίζει η Ομοσπονδία.

Εάν οι καταγγελίες ευσταθούν τότε οι ανοσοκατεσταλμένοι ασθενείς, όπως είναι οι αιμοκαθαρόμενοι, κινδυνεύουν άμεσα.
«Οι νεφροπαθείς μετά την αιμοκάθαρση πάνε σπίτι τους… Εάν καταλήξουν αιτία θανάτου δηλώνεται λοίμωξη, μικροβιαιμία ή άλλη αιτία» αναφέρει σχετικά η ΠΟΕΔΗΝ, υπονοώντας ότι ενδέχεται να υποδηλώνονται οι θάνατοι από τις ενδονοσοκομειακές λοιμώξεις.
«Ο πρόχειρος τρόπος αντιμετώπισης των Νοσοκομειακών Λοιμώξεων από την κυβέρνηση είναι ανεπίτρεπτος. Τη στιγμή που διαθέτει 350.000 ευρώ το μήνα για την φύλαξη των ντουβαριών του ΚΕΕΛΠΝΟ σε Ιδιωτική Εταιρεία Φύλαξης, δεν διαθέτει χρήματα να αγοράσει αντιδραστήρια προκειμένου να εξοπλίσει το Κεντρικό Εργαστήριο Δημόσιας Υγείας (ΚΕΔΥ) που έχει αποκλειστικά την ευθύνη να διενεργεί τους μικροβιολογικούς και χημικούς ελέγχους στα δείγματα που αποστέλλουν οι Επιτροπές Λοιμώξεων των Νοσοκομείων.
Χάνουν το νόημα οι λέξεις: ανικανότητα, σκοπιμότητα, πλήρης διάλυση. Κρίμα για τους ασθενείς» καταλήγει στην ανακοίνωσή της η Ομοσπονδία.

Comments (0)